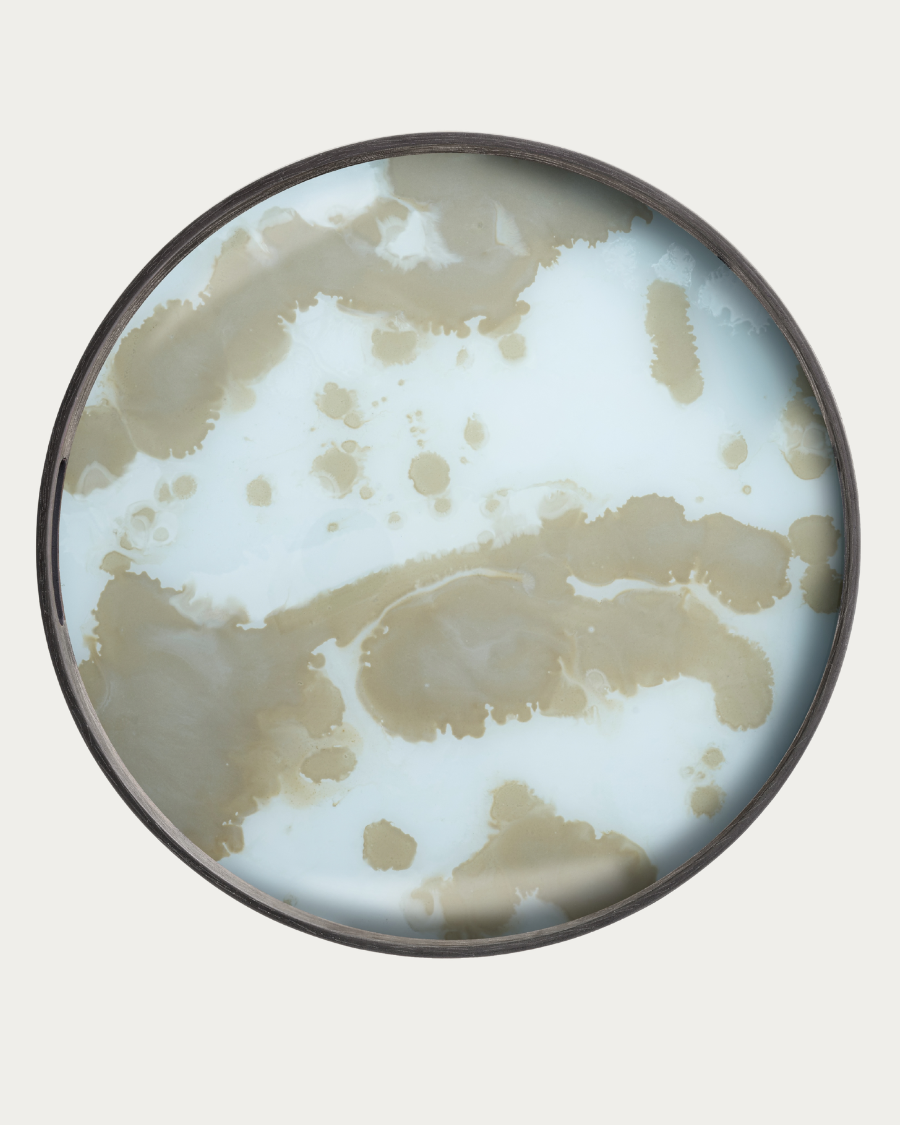
Plateau CLASSICS ORGANIC Indigo - Ø48

Plateau CLASSICS ORGANIC Indigo - Ø48
Taxes inclues Frais d'envoi calculés au paiement
Lieferzeit: 3-4 semaines
Conseil personnalisé
7/7, de 9 h à 18 h +32 485 55 69 25
Par e-mail à l'adresse info@homestorys.com
Le plateau CLASSICS ORGANIC Indigo d'Ethnicraft est plus qu'un simple accessoire fonctionnel - c'est une véritable œuvre d'art qui rehausse votre intérieur. Inspiré par les riches empreintes et motifs tribaux d'Afrique et d'Indonésie, ce plateau associe des couleurs luxuriantes à des tons neutres sourds pour créer un équilibre harmonieux. La représentation vivante et la fluidité des motifs reflètent l'inspiration mondiale que la designer Dawn Sweitzer a captée dans chaque détail.
La pièce maîtresse de ce plateau est son design impressionnant. Les différentes nuances de couleurs rappellent le mouvement dynamique d'un déferlement sauvage ou la forme douce d'un gros nuage. La touche artistique de Dawn Sweitzer se reflète dans la finition raffinée et le choix minutieux des couleurs, ce qui fait que le plateau n'est pas seulement fonctionnel, mais constitue également un point fort décoratif dans chaque pièce.
Fabriqué en verre de haute qualité, les couleurs sont appliquées à la main, ce qui donne de la profondeur à chaque couche et fait jaillir les couleurs de manière vivante. Grâce à la fabrication à la main, chaque plateau est unique, les petites imperfections soulignant le caractère individuel. Vous obtenez ainsi une pièce vraiment unique, qui servira à la fois d'accessoire élégant et d'élément pratique dans votre intérieur.
Le plateau CLASSICS ORGANIC Indigo n'est pas seulement beau à voir, il témoigne aussi du savoir-faire artisanal et de la vision créative d'Ethnicraft. C'est le choix parfait pour tous ceux qui attachent de l'importance aux objets design exclusifs et de qualité qui racontent des histoires et enrichissent les espaces.
Informations sur le produit
20360 (indigo) 20361 (Merde d'or) 20371 (Brume bleue)
SKU (référence de l'article)
Taille
48x48x4cm
poids total
2 kg
Matériel
Verre peint à la main - bord en bois
Couleurs
Coloré | Le noir
garantie
Garantie constructeur 2 ans
Utilisation et entretien optimaux :
En raison de la nature artisanale de nos produits, chaque article variera légèrement. Nous considérons cela comme un signe d'unicité.
Pour une utilisation en intérieur uniquement.
Utilisez un chiffon doux et sec pour un dépoussiérage régulier. Nous vous recommandons d'utiliser des sous-verres et de les enlever immédiatement avec un chiffon humide en cas de déversement.
L'histoire de la famille de Ethnicraft
Choisir les options

Un design intemporel

Durabilité et longévité

Artisanat de Belgique

